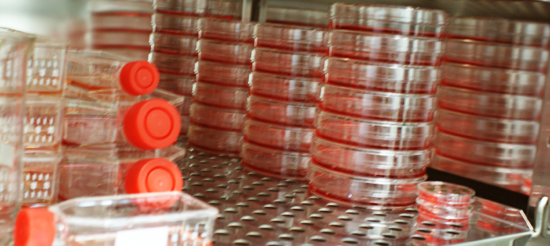
image of the lab

| NOW | Abstract Submission Open |
| 5 October 2011 | Abstract Submission Deadline |
| 17 October 2011 | Notification of the presenting authors of the selection of Oral/ Poster presentation |
Rua do Campo Alegre, 823, 4150-180 Porto - Portugal
Tel +351 226 074 900 . Fax +351 226 099 157 . Email: info@ibmc.up.pt